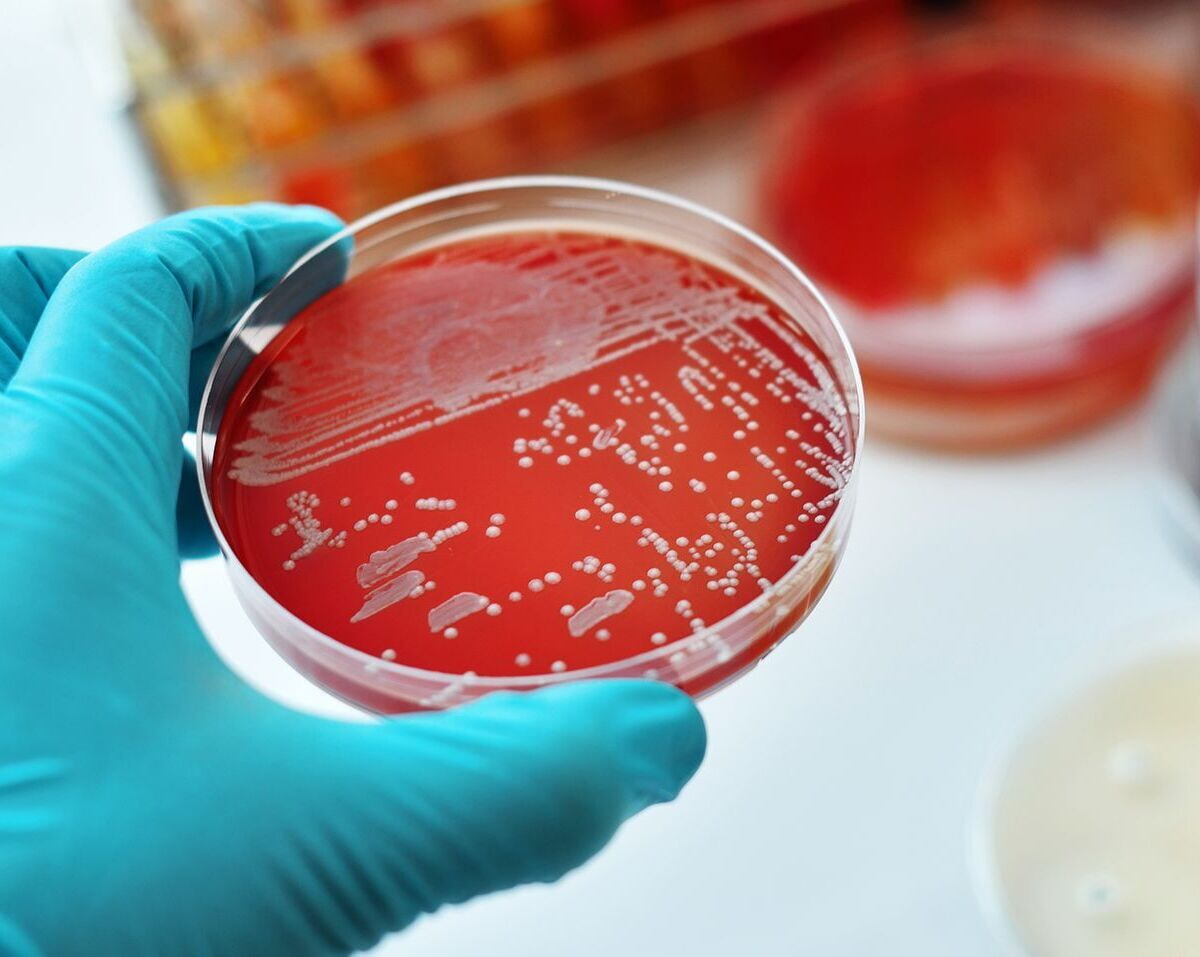
Bakterium Petri 1000 1200x957

CCCZ Präzisionsonkologie – Innovationen für eine personalisierte Krebsmedizin
CCCZ Leuchtturmprojekte verfolgen ein klares Ziel: neue wissenschaftliche Erkenntnisse schneller in präzisere Diagnosen und individuell zugeschnittene Therapien für Patient:innen zu überführen.
In diesen Projekten treffen innovative Forschungsideen auf interdisziplinäre Zusammenarbeit. So entstehen neue Ansätze, die das Potenzial haben, die Krebsmedizin nachhaltig zu verbessern. Unterstützt werden die Projekte durch Gelder der Universitären Medizin Zürich (UMZH). Durch die Evaluierung aller Projekte durch unabhängige Expert:innen stellt das CCCZ sicher, dass besonders vielversprechende und innovative Forschungsprojekte realisiert und gezielt vorangebracht werden.

Zürcher Konsortium für Präzisionsonkologie
INTeRCePT3.0
Dynamische, individualisierte Risikovorhersage zur Verbesserung der Behandlung von Lymphomen


CCCZ Klinische Studie
MIRACLE
Eine Phase-I-Studie zur Bewertung der Sicherheit und der immunologischen Effekte multifunktionaler mRNA-basierter CAR-Immunzellen bei refraktärem Glioblastom

CCCZ Klinische Studie
BRAVE-Lung
Robotergestützte bronchoskopische Radiofrequenzablation bei Lungenkrebs im Frühstadium - eine neuartige Krebstherapie

CCCZ Lighthouse Project
IMMUNO-CAR ZURICH
Innovative Zelltherapien für eine gezielte Krebsbehandlung

CCCZ Leuchtturmprojekt
OMD-ZH
Oligometastasierung besser verstehen, gezielter behandeln
CCCZ Lighthouse Project
CANCER MICROBIOME
Darmbakterien, die smarten Helfer gegen Krebs

CCCZ Leuchtturmprojekt
PROMIS
Präzisionsonkologie zur Verbesserung der Überlebenschancen von Krebspatienten mit ZNS-Metastasen